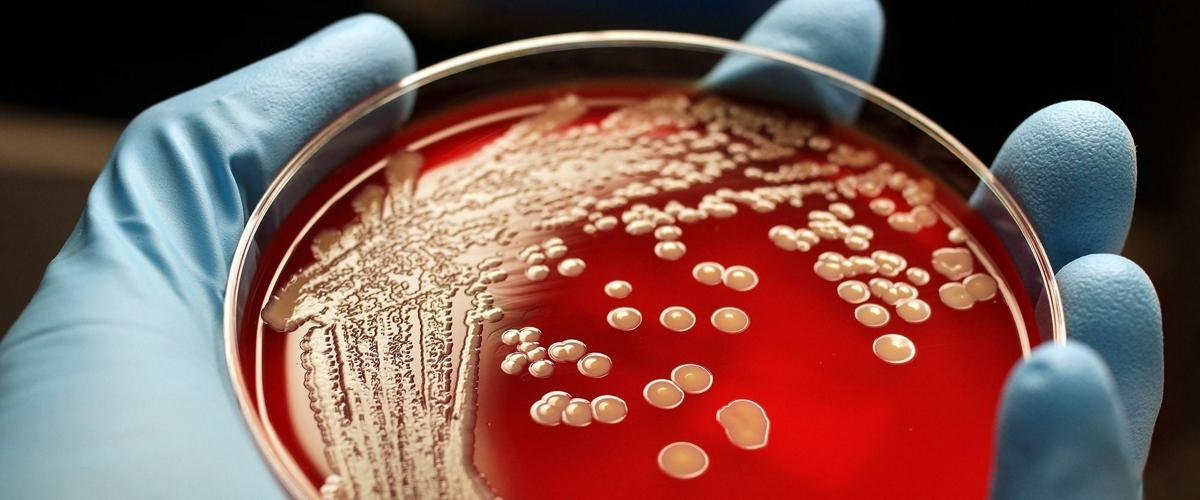
TODO:

Сопротивляемость антибактериальным препаратам только в Евросоюзе приводит ежегодно к 25 000 летальных исходов. По прогнозам, если решение этой проблемы не будет найдено, к 2050 каждый год от инфекций, вызванных резистентностью, будет умирать свыше 10 млн человек. При этом новых препаратов от грамотрицательных бактерий врачи не получали уже 50 лет.
В прошлом команда ученых из Университета Шеффилда разработала соединение, воздействующее на грамположительные бактерии, но новый состав обладает противомикробным действием широкого спектра, то есть эффективен и против грамотрицательных бактерий.
Кроме того, он обладает люминесцентными свойствами. Это значит, что врачи могут следить за приемом препарата и его действием на бактерии с помощью передовых технологий микроскопии, сообщает Phys.org.
Грамположительные штаммы бактерий особенно сложно лечить, так как оболочки хорошо защищают клетки от проникновения лекарств внутрь этих болезнетворных микроорганизмов, а сами они вызывают пневмонию, инфекции мочевых путей и кровотока.
«Проблема противомикробной резистентности встает все более остро, и многие исследования предсказывают глобальную чрезвычайную ситуацию, так что срочно необходим широкий спектр противомикробных препаратов, эффективных против резистентных патогенов, — заявил профессор Джим Томас, руководитель научной группы.
Исследователи из Ратгерского университета и Рочестерского технологического института разработали миниатюрное устройство, которое поможет в борьбе с резистентными микроорганизмами. Оно улавливает болезнетворные бактерии из образцов крови и позволяет врачам выявить устойчивые к лекарствам штаммы и назначить оптимальное лечение.